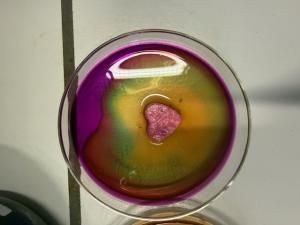

| Bild | Titel | Klassen | Module | Teilgebiete |
|---|---|---|---|---|
 |
Absorptionsspektrum von Blattfarbstoffen | Klasse 9 Klasse 10 |
9.4 - Wahlbereich 9 10.5 - Wahlbereich 10 |
Arbeitstechniken Stoffeigenschaften Stofftrennung |
 |
Analyse Stadtgasoxid | Klasse 8 |
8.4 - Wasser - eine Verbindung |
Oxidation und Reduktion |
 |
Beschichtung von Kupfer mit Laurinsäure (Nanochemie) | Q4 |
Q4 - Elektrochemie |
Stoffeigenschaften |
 |
Bindung von Kohlenstoffdioxid durch Kaliumhydroxid | Klasse 9 |
9.3 - Säuren und Laugen - echt ätzend |
Säuren und Basen |
 |
Blutnachweis mit Wasserstoffperoxid | Klasse 9 |
Nachweis |
|
 |
Chlorwasserstoff-Springbrunnen | Klasse 9 |
9.3 - Säuren und Laugen - echt ätzend |
Säuren und Basen |
 |
Dünnschichtchromatographie und Nachweis von Aminosäuren | Q1 |
Q1 - Proteine |
Nachweis Stofftrennung |
 |
Einfluss des Drucks auf das chemische Gleichgewicht | Q2 |
Q2 - Chemisches Gleichgewicht |
Säuren und Basen chemisches Gleichgewicht |
 |
Elektrochemische Spannungsreihe (Mikromaßstab) | Q4 |
Q4 - Elektrochemie |
Elektrochemie |
 |
Elektrolyse von Wasser (Schüler:innen-Experiment) | Klasse 8 |
8.4 - Wasser - eine Verbindung |
Elektrochemie |
 |
Enzymatische Zersetzung von Wasserstoffperoxid | Q2 |
Q2 - Reaktionsgeschwindigkeit und Katalyse |
Nachweis Reaktionsgeschwindigkeit |
 |
Fluoreszenz organischer Farbstoffe am Beispiel Riboflavin | Klasse 10 Q3 |
10.5 - Wahlbereich 10 Q3 - Indikatorfarbstoffe |
Oxidation und Reduktion |
 |
Landolt-Reaktion; Iod-Uhr | Q2 |
Q2 - Reaktionsgeschwindigkeit und Katalyse |
Reaktionsgeschwindigkeit |
 |
MacGyver-Batterie | Q4 |
Q4 - Elektrochemie |
Elektrochemie |
 |
Pyrophores Eisen (Nanochemie) | Q4 |
Q4 - Elektrochemie |
Oxidation und Reduktion Elektrochemie |
 |
Reaktion von Chlorwasserstoff mit Ammoniak | Klasse 9 |
9.3 - Säuren und Laugen - echt ätzend |
Säuren und Basen |
 |
Reaktion von Kupfer und Schwefel | Klasse 8 |
8.1 - Faszination Chemie - Feuer, Schall und Rauch |
Stoffeigenschaften |
 |
Reaktionsgeschwindigkeit am Bsp. Mg mit HCl | Q2 |
Q2 - Reaktionsgeschwindigkeit und Katalyse |
Reaktionsgeschwindigkeit |
 |
Redoxreaktion zwischen Eisen und Kupfersulfat | Q3 |
Q3 - Redoxreaktionen |
Oxidation und Reduktion |
|
Reduktion von Permanganat mit Glucose | Q3 |
Oxidation und Reduktion |
|
 |
Reduktion von Silberoxid (Demo-Experiment) | Klasse 8 |
9.2 - Metalle - Schätze der Erde |
Oxidation und Reduktion |
 |
Synthese von Polyestern | Q1 |
Q1 - Kunststoffe - problematische Alleskönner |
Hydrolyse und Kondensation organische Synthese |
 |
Unterscheidung von Cola und Cola Zero (Fehling-Probe) | Klasse 9 |
9.4 - Wahlbereich 9 |
Nachweis |
 |
Verbrennung von Methan | Klasse 10 |
Oxidation und Reduktion Nachweis |
|
 |
Zerteilungsgrad - Eisen brennt doch? | Klasse 8 |
8.1 - Faszination Chemie - Feuer, Schall und Rauch |
Stoffeigenschaften |